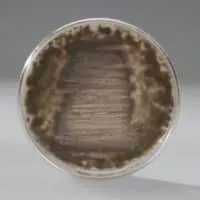

Penicillium Camemberti
| Use attributes for filter ! | |
| Scientific name | Penicillium camemberti |
|---|---|
| Higher classification | Penicillium |
| Order | Eurotiales |
| Rank | Species |
| Family | Trichocomaceae |
| Kingdom | Fungi |
| Date of Reg. | |
| Date of Upd. | |
| ID | 2388888 |
About Penicillium Camemberti
Penicillium camemberti is a species of fungus in the genus Penicillium. It is used in the production of Camembert, Brie, Langres, Coulommiers, and Cambozola cheeses, on which colonies of P. camemberti form a hard, white crust. It is responsible for giving these cheeses their distinctive flavors.